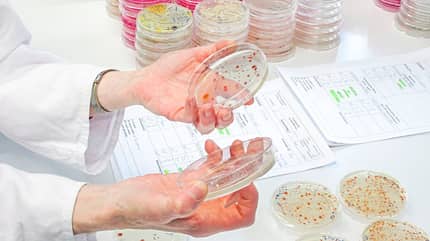

Gelbhafer
Das Produkt: Gelbhafer von überregionalem Futter-Anbieter, abgefüllt im September 2021, keine Angaben zur Reinigung.

Litergewicht: 519 Gramm (siehe Abschnitt "Litergewicht"), was auf einen qualitativ hochwertigen Hafer mit ausreichend Energie hindeutet.
Glas-Wasser-Test: Etwas mehr als die Hälfte des Hafers sinkt beim Glas-Wasser-Test (siehe Abschnitt "Der Glas-Wasser-Test") zu Boden. Das Wasser trübt sich nach 20 Minuten gelblich, aber nur leicht. Auch Schwebstoffe sind im Wasser erkennbar.
Laborergebnis: Bei dieser Probe liegt ein leicht erhöhter Gehalt an produkttypischen Schimmelpilzen vor. KBE/g gibt die Anzahl der koloniebildenden Einheiten pro Gramm Probe an. Die Orientierungswerte für Hafer finden Sie Abschnitt "Der Test im Labor".
Bakterien (mesophil, aerob) KBE/g: Prüfergebnis 29.000.000
Hefen KBE/g: Prüfergebnis 105.000
Schimmelpilze KBE/g: Prüfergebnis 236.000 (KG4 und KG5)
Tierische Vorratsschädlinge: nicht nachgewiesen
Bei den Bakterien wurde die Keimgruppe KG1, also feldbürtige, für das Produkt typische Bakterien gefunden. Bei den Schimmelpilzen fand das Labor neben Keimgruppe 4 (KG4, feldbürtige Pilze; 210 000 KBE/g) auch KG5, Verderb anzeigende Pilze. Mit 26.000 KBE/g war der Orientierungswert von 50.000 KBE/g jedoch nicht überschritten, während der Wert der KG4 leicht erhöht war. Der Orientierungswert liegt hierfür bei 200.000 KBE/g. Der Wert für die Hefen ist ebenfalls unterhalb des Orientierungswerts von 200.000 KBE/g.
Zusätzlich prüft das Labor, wie feucht der Hafer ist. Denn durch Restfeuchte können sich Keime bilden. Diese Probe ist sehr trocken:
Trockenmasse: 87,7 %
Wasser: 12,3 %
Rohasche (XA): 2,2 %
Sinnesprüfung: Es sind viele andere Pflanzenteile sichtbar. Auch riecht der Hafer etwas staubiger als die anderen Proben, allerdings kein bisschen unangenehm.
Fazit: Ein Hafer, der augenscheinlich einen guten Eindruck macht, dessen Qualität aber geringgradig herabgesetzt ist. Verfüttert werden dürfte er trotzdem, da die Laborergebnisse die Qualitätsstufe II erfüllen.
Schwarzhafer
Das Produkt: Gereinigter und entspelzter Schwarzhafer von überregionalem Futter-Anbieter, haltbar bis Juni 2022

Litergewicht: 590 Gramm, was auf einen qualitativ sehr hochwertigen Hafer hinweist, in dem ausreichend Energie steckt und der wenig mit Keimen belastet ist. Das Gewicht ist sogar besser als angegeben.
Glas-Wasser-Test: ¾ des Hafers sinkt zu Boden. Ein Zeichen dafür, dass es sich um qualitativ wertvolles Getreide handelt. Das Wasser trübt sich nur minimalst, man muss schon sehr genau hinsehen.
Laborergebnis:
Die ermittelten Keimgehalte liegen alle innerhalb der Orientierungswerte. Es gibt also keinen Hinweis auf mikrobiellen Verderb.
Bakterien (mesophil, aerob) KBE/g: Prüfergebnis 24.000.000
Hefen KBE/g: Prüfergebnis 14.500
Schimmelpilze KBE/g: Prüfergebnis 158.000
Tierische Vorratsschädlinge: nicht nachgewiesen
Bei den Bakterien wurde nur die Keimgruppe KG1 gefunden. Das sind feldbürtige, also für das Produkt ganz typische Bakterien wie zum Beispiel Gelbkeime, Pseudomonaden und Enterobacteriaceae.
Bei den Schimmelpilzen fanden die Forscher im Labor die Keimgruppen KG4 und KG5. KG4 steht für feldbürtige, also typische Pilze. Der Wert lag bei 140.000 KBE/g (Orientierungswert: 200.000 KBE/g). KG5 gibt Verderb anzeigende Pilze wie Aspergillen und Penicillien an. Allerdings lag der Wert mit 18.000 KBE/g deutlich innerhalb der Orientierungswerte (50.000 KBE/g). Hefen sind in dieser Probe kaum vertreten. Der Orientierungswert liegt bei 200.000 KBE/g.
Auch diese Probe ist sehr trocken. Das ist gut, da so keine Keimbelastung durch Restfeuchte entstehen kann.
Trockenmasse: 87,5 %
Wasser: 12,5 %
Rohasche (XA): 2,3 %
Sinnesprüfung: Diese Hafer-Probe sieht sehr sauber aus, riecht allerdings ein klein wenig staubig. Doch es kommt auch die typisch nussige Hafernote durch. Die entnommene Probe ist sehr rein, es sind keine anderen Pflanzenteile zu erkennen. Bei einer Handvoll Hafer sind bis auf zwei Körner tatsächlich alle entspelzt.
Fazit: Ein mikrobiologisch einwandfreies Produkt, dessen Werte alle innerhalb der Orientierungswerte liegen und das laut Glas-Wasser-Test und Litergewicht dem Pferd viel Energie liefert.
Gelbhafer von der Mühle
Das Produkt: Gelbhafer, klassisches Mühlenprodukt aus baden-württembergischem Anbau, keine Angaben zur Reinigung des Hafers. Die Probe wurde Anfang November direkt im Stall gezogen.

Litergewicht: Mit einem Gewicht von 532 Gramm scheint diese Probe ein qualitativ guter Hafer zu sein. Jedoch haben wir hier nicht nur Hafer erfasst, sondern auch Erdkrümel und andere Pflanzenteile.
Glas-Wasser-Test: Bei dieser Hafer-Probe sinkt etwa die Hälfte der Körner zu Boden. Ein Zeichen, dass es sich, verglichen mit den anderen drei Proben, um minimal weniger wertvollen Hafer handelt. Das Wasser verfärbt sich kaum, allerdings sieht man Erdkrümel im Wasser schwimmen und recht viele Schwebteilchen.
Laborergebnis: Kein Hinweis auf mikrobiellen Verderb; die Keimgehalte liegen alle innerhalb der Orientierungswerte.
Bakterien (mesophil, aerob) KBE/g: Prüfergebnis 23.000.000
Hefen KBE/g: Prüfergebnis 140.000
Schimmelpilze KBE/g: Prüfergebnis 109.000
Tierische Vorratsschädlinge: nicht nachgewiesen
Bei den Bakterien wurde im Labor lediglich die Keimgruppe KG1 gefunden, sprich feldbürtige, für das Produkt typische Bakterien wie Gelbkeime, Pseudomonaden und Enterobacteriaceae.
Bei den Schimmelpilzen fanden die Forscher die Keimgruppen KG4 und KG5. KG4 steht für feldbürtige, also typische Pilze. Der Wert lag bei 100.000 KBE/g, während der Orientierungswert mit 200.000 KBE/g angegeben ist. KG5 gibt Verderb anzeigende Pilze wie Aspergillen und Penicillien an. Der Wert war allerdings mit 9.000 KBE/g sehr gering und deutlich innerhalb der Orientierungswerte (50.000 KBE/g).
Auch in dieser Probe lag der Wert für Hefen mit 140.000 KBE/g innerhalb des Orientierungswerts von 200.000 KBE/g
Auch dieser Hafer ist nach der Ernte schön durchgetrocknet, so dass sich keine Keime aufgrund von Restfeuchte bilden können.
Trockenmasse: 88,0 %
Wasser: 12,0 %
Rohasche (XA): 2,7 %
Sinnesprüfung: Optisch und vom Geruch her unterscheidet sich dieses Mühlenprodukt von den abgepackten Hafer-Proben aus dem Handel. Dieser Hafer enthält sehr viele andere Pflanzenteile, es sind stellenweise sogar Disteln zu erkennen. Der Hafer riecht auch staubiger als die anderen drei Produkte. Die Ergebnisse der Sinnesprüfung waren zu erwarten, da der Hafer direkt von der Mühle stammt. Er wird vor dem Verkauf nicht aufwendig gereinigt.
Fazit: Ein Hafer, der mikrobiologisch einwandfrei ist, auch wenn die Sinnesprüfung das nicht vermuten ließ. Die Untersuchung im Labor war hier aufschlussreich.
Skandinavischer Hafer
Das Produkt: Finnischer und schwedischer Hafer gemischt, sehr schwer, zweifach gereinigt von überregionalem Anbieter, keine Angaben zum Abfülldatum.

Litergewicht: 605 Gramm, was für einen qualitativ sehr hochwertigen Hafer spricht. Durch die Angaben des Abfüllers war das hohe Litergewicht zu erwarten. Der Käufer bekommt, was auf dem Sack steht.
Glas-Wasser-Test: ¾ des Hafers sinkt im Wasserglas zu Boden. Das Wasser bleibt auch nach 20 Minuten glasklar, es sind nur ganz wenige Schwebstoffe im Wasser zu erkennen. Auch dieser Test deutet auf einen sehr hochwertigen Hafer hin.
Laborergebnis: Die ermittelten Keimgehalte liegen alle sehr weit unterhalb der Orientierungswerte. Kein Hinweis auf mikrobiellen Verderb.
Bakterien (mesophil, aerob) KBE/g: Prüfergebnis 60.000
Hefen KBE/g: Prüfergebnis <500
Schimmelpilze KBE/g: Prüfergebnis <500
Tierische Vorratsschädlinge: nicht nachgewiesen
Bei den Bakterien wurden lediglich feldbürtige Bakterien wie Gelbkeime, Pseudomonaden, Enterobacteriaceae und ähnliche gefunden (KG1). Hefen und Schimmelpilze konnten die Forscher kulturell gar nicht nachweisen. Der Hafer ist wirklich sehr sauber.
Auch diese Probe ist sehr gut getrocknet. So entsteht keine Keimbelastung durch Restfeuchte in den Körnern.
Trockenmasse: 88,7 %
Wasser: 11,3 %
Rohasche (XA): 2,5 %
Sinnesprüfung: Typischer, angenehmer Hafer-Geruch, ganz leicht staubig. Allerdings ohne die nussige Note wie beim Schwarzhafer. Optisch ein sehr sauberer Hafer, es sind keine anderen Pflanzenteile oder Verunreinigungen zu erkennen.
Fazit: Dieser Hafer macht nicht nur bei der Sinnesprüfung einen sehr guten Eindruck, sondern auch sein Laborergebnis fällt sehr gut aus. Die untersuchte Hafer-Probe ist sehr hochwertig und sauber.
Der Glas-Wasser-Test
Eine Handvoll Hafer in einem Glas voll Wasser verrät in wenigen Minuten, wie gut der Hafer ist. Ein schneller, günstiger und einfacher Test, den Dr. Dorothe Meyer, Fütterungsexpertin der Firma Iwest in Hohenpeißenberg/Bayern, entwickelt hat.
Sofort zeigt sich, wie schwer der Hafer ist: Je mehr Körner sich am Boden sammeln, desto hochwertiger der Hafer. Trübt sich das Wasser, ist der Hafer dreckig. Auch Milbenkot und Erdkrümel werden sichtbar. Lassen Sie das Glas weitere 20 Minuten stehen. Färben sich die Körner rot, haben sich Pilze im Hafer eingenistet. Schimmelige Stellen werden dunkel; unreifes Getreide wird grün. Verfärbungen einzelner Körner sind nicht schlimm. Ist aber der ganze Glasinhalt bunt, sollten Reiter den Hafer nicht mehr füttern, sondern wegschmeißen.
Der Test im Labor
Aufschluss, wie sauber die Haferportion ist, gibt die Laboruntersuchung. Wir haben vier Proben ans Labor der Landwirtschaftskammer NRW (LUFA NRW) in Münster geschickt. Dort wurde der Hafer mikrobiologisch auf Bakterien, Hefen, Schimmelpilze und Vorratsschädlinge geprüft.
Die mikrobiologische Qualität von Futtermitteln wird mit Orientierungswerten beurteilt – vertretbare Obergrenzen, bis zu denen die mikrobiologische Qualität als normal eingestuft wird. Gezählt werden die koloniebildenden Einheiten pro Gramm Probe (KBE/g).
Orientierungswerte für Hafer:
Bakterien (mesophil, aerob) x 106 KBE/g
Keimgruppe 1: 50
Keimgruppe 2: 1
Keimgruppe 3: 0,05
Schimmel- und Schwärzepilze x 103 KBE/g
Keimgruppe 4: 200
Keimgruppe 5: 50
Keimgruppe 6: 2
Hefen x 103 KBE/g
Keimgruppe 7: 200
Litergewicht
Zentrales Qualitätskriterium im Handel ist das Hektolitergewicht. Sehr guter Hafer wiegt über 54 Kilogramm pro 100 Liter. Das Litergewicht können Sie ganz einfach vor Ort im Stall bestimmen: Mit dem Messbecher einen Liter ungequetschte Körner abmessen und mit einer Haushaltswaage wiegen.
Unter 400 Gramm Gewicht ist weniger wertvoller Hafer, 450 bis 500 Gramm sind normal, über 500 Gramm sehr gut. Achtung: Die Werte von gequetschtem Getreide liegen rund 25 bis 30 Prozent unter dem Gewicht ganzer Körner.
Was sagt das Litergewicht über die Qualität? Je schwerer das Getreide, desto keimfreier ist es. Das wurde in mehreren Studien wissenschaftlich untersucht. Aber enthält schwerer Hafer dann auch mehr oder bessere Inhaltsstoffe? Ja. Je schwerer das Korn, desto mehr Stärke (Kohlenhydrate) steckt drin.
Das Litergewicht gilt seit Jahrzehnten als Qualitätsmerkmal beim Getreidekauf. Je schwerer der Hafer, desto teurer ist er. Denn in großen, runden Körnern steckt eben mehr Energie als in kleinen, schmalen Körnern. Achten Sie daher bei der täglichen Portion Hafer auf das Gewicht, nicht auf das Volumen.
Sinnesprüfung
So erkennen Sie guten Hafer:
Farbe: Weiß, gelb oder schwarz. Graue Stellen sind Schimmel, grüne Körner sind unreif.
Geruch: Nussig. Der Hafer sollte nicht muffig, ranzig, sauer oder nach Stall riechen.
Geschmack: Süßlich, nussig. Sonst ist das Getreide unreif, verdorben oder schimmelig. Schmeckt der Hafer bitter, sollten Sie ihn wegwerfen.
Wie stark ist Getreide mit Pestiziden belastet?
Glyphosat ist in Sachen Pestizidrückständen der Aufreger schlechthin. Bei Jenke von Wilmsdorff, TV-Experimentator, stellten Ärzte bei seinem neuesten "Food Experiment" einen erschreckend hohen Wert an Glyphosat in seinem Blut fest. Er hatte wochenlang belastete Lebensmittel gefuttert.
Das CVUA (Chemisches und Veterinäruntersuchungsamt) Stuttgart untersuchte von 2010 bis 2019 insgesamt 17.222 Proben konventionell und ökologisch erzeugtes Obst und Gemüse, darunter auch Getreide, auf Glyphosat. Rückstände oberhalb der Bestimmungsgrenze (0,02 mg/kg) wurden in nur 78 Proben nachgewiesen. 72 der 78 positiv getesteten Proben stammen aus konventionellem, 6 aus ökologischem Anbau.
Auch Ökotest machte sich 2021 auf die Suche nach Schadstoffen in Haferflocken. Glyphosat fanden die Tester kaum, dafür jede Menge Nickel und Schimmelpilzgifte.





